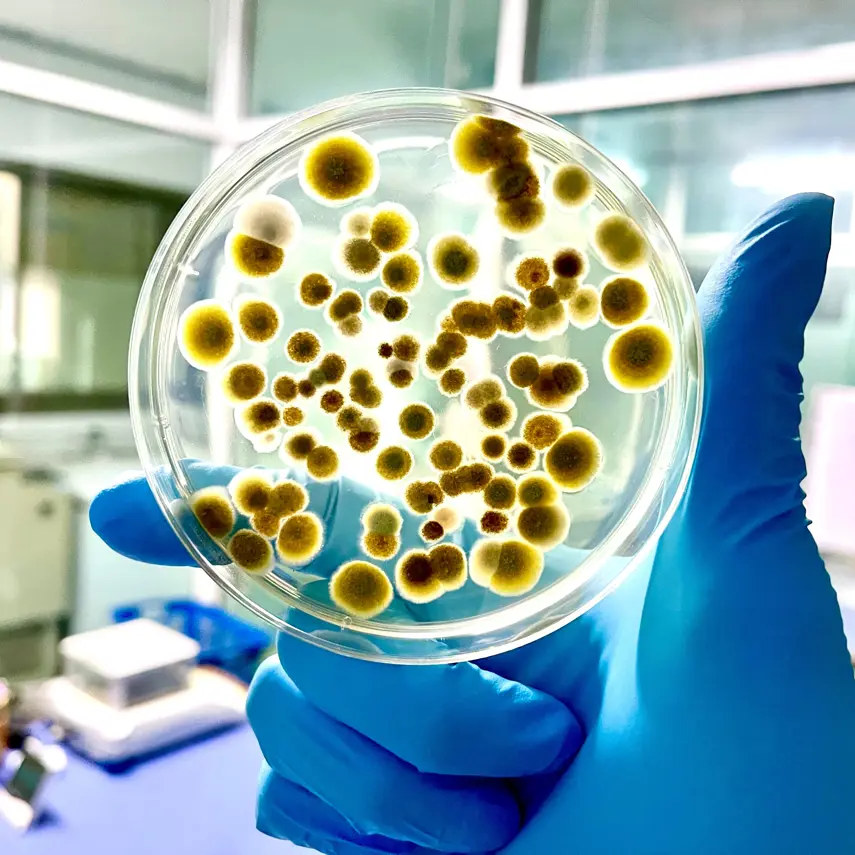

Breathing new life into the treatment of lung cancer
- Location
- Berwick, Gippsland
- Value
- $50,000
- Open date
- 02/04/2026
- Close date
- 16/04/2026
- Study sector
- Higher education
- Study level
- Higher Degree by Research
- Student type
- Domestic
- Student status
- New / commencing
- Scholarships available
- 1
Project Details
This PhD project will focus on the development and preclinical testing of ‘immuno-chemo’ therapeutics that can effectively target cancer cells and ‘switch on’ or activate immune cells (macrophages, lymphocytes) to provide an effective NSCLC treatment with fewer systemic side-effects typically seen in current available cancer therapies. The project will be conducted in collaboration with Monash Institute of Pharmaceutical Sciences and Industry Partner Allergenix Pty Ltd, and will provide exciting new opportunities to study disease progression and a pathway for a novel inhaled therapy ready for commercialisation and transition to the clinic.
Scholarship Details
Supervisors
Professor David Piedrafita is internationally recognised as one of the leading authorities of immunological responses for parasites in veterinary animals and has worked at major universities both in Australia and overseas. In this project, he will be principal supervisor.
A/Prof Bischof's research interests are focused on immune-related conditions, particularly the pathophysiology of airway disease and translational research studies. For this project he will be the Industry Co-Supervisor, a direct link for the candidate to Allergenix PTY LTD.
By combining large animal (sheep) models with advanced molecular biology techniques, Dr Derseh investigates disease mechanisms and evaluates novel therapeutic strategies in collaboration with both academic and industry partners. Dr Derseh is in the Associate Supervisor role for this project.
